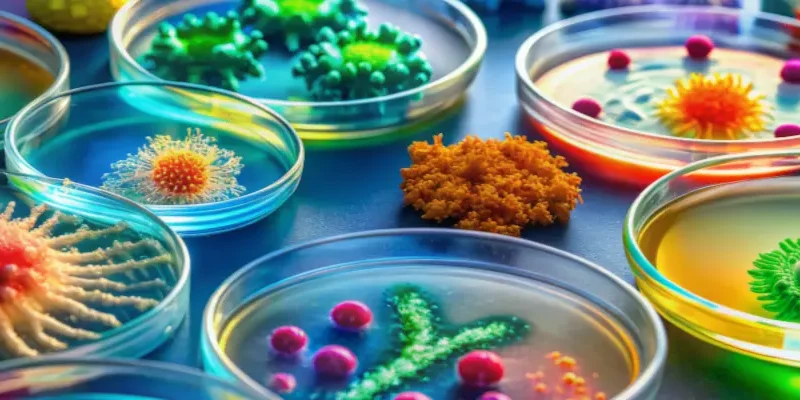
several items in petri dishes
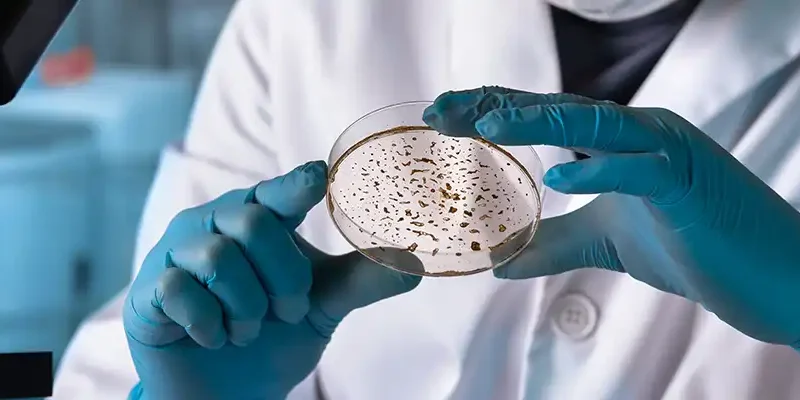
close up of hands holding a petri dish for examination

Academics

MajorOn Campus

MajorOn Campus

MinorOn Campus
MajorOn Campus

MajorOn Campus

Accelerated Graduate DegreeOn Campus

Master'sOn Campus
DoctoralOn Campus